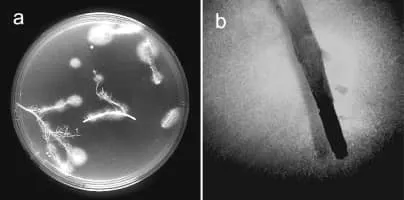

Fusarium Verticillioides
| Use attributes for filter ! | |
| Scientific name | Fusarium verticillioides |
|---|---|
| Class | Sordariomycetes |
| Phylum | Ascomycota |
| Order | Hypocreales |
| Rank | Species |
| Subclass | Hypocreomycetidae |
| Date of Reg. | |
| Date of Upd. | |
| ID | 2356578 |
About Fusarium Verticillioides
Fusarium verticillioides is the most commonly reported fungal species infecting maize. Fusarium verticillioides is the accepted name of the species, which was also known as Fusarium moniliforme. The species has also been described as mating population A of the Fusarium fujikuroi species complex.